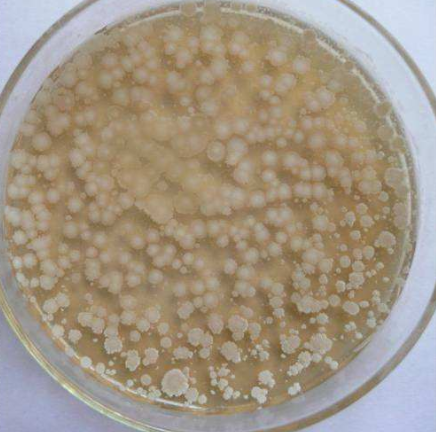
产品封面图

万千商家帮你免费找货
0 人在求购买到急需产品
- 详细信息
- 询价记录
- 文献和实验
- 技术资料
- 库存:
大量
- 英文名:
CephalosporiumacremoniumCorda
- 保质期:
1-2年
- 供应商:
上海联迈生物工程有限公司
- 保存条件:
斜面菌种:1-2个月。冻干菌种:5-10年
- 规格:
冻干粉一支
顶头孢霉
资源名称 顶头孢霉
种属 CephalosporiumacremoniumCorda
安全等级 1
模式菌株 no
培养方法
培养基 14,17
生长条件 25-28℃
收到菌株操作:
1、安瓿瓶开封:用浸过75%酒精的脱脂棉擦净安瓿管,用火焰加热其顶端,滴少量无菌水至加热顶端使之破裂,用锉刀或者镊子敲下已破裂的安瓿管顶端。
2、菌株恢复培养:用无菌吸管吸取0.3--0.5ml适宜的液体培养基,滴入安瓿管内,轻轻振荡,使冻干菌体溶解呈悬浮状。吸取全部菌体悬浮液,移植于1-2支建议的培养基试管中,并在建议的条件下培养。
3、注意事项:菌种活化前,请将安瓿管保存在6-10℃的环境下,某些菌种经过冷冻干燥保存后,延迟期较长,需要连续两次继代培养才能正常生长
4、复苏后的菌种在传1-2代后使用。
5、暂不启开的安瓿及复苏后需保藏的斜面应于4℃中保藏。
顶头孢霉低温存法
①简单保存法,将琼脂斜面孢子培养物、菌丝悬浮液以及由麸皮、大米、小米等谷物原料制成的孢子培养物置于4℃冰箱保存,保存时间不超过1~2个月,若将谷物原料制备的孢子瓶抽真空并在棉塞上浸蜡,以隔绝外界空气和水汽,保持时间可达3~4个月;②液氮超低温保存法,将生长稳定期的细胞悬浮在10%甘油或其他低冰点液体中,密封于安瓿管内,然后控制冷却速度,使安瓿管温度逐步下降至 -35℃时,即可置于-150~-196℃的液氮罐中保存。大多数微生物如病毒、噬菌体、多种细菌、放线菌、酵母和原虫、特别是一些用冷冻干燥法有困难的微生物,都可用此法长期保存。
顶头孢霉脱水存法
①沙土保存法,能产孢子的细菌、放线菌及霉菌可采用此法保存,即将沙和土以3:2比例混合,经稀酸处理洗净过筛,装入小试管内,装置高度为1cm;灭菌2~3次,烘干后即可将在斜面培养基上生长良好的孢子,用无菌蒸馏水2~2.5ml制成孢子悬液,吸取少许加入沙土管中,经真空抽干,外观呈松散状态,于4℃冰箱保存,保存期可达5~7年。
② 冷冻干燥法,将孢子悬浮液与保护剂(一般用脱脂牛奶或血清)相混合,放在安瓿管内于-20~-30℃的乙醇浴中速冻。然后,在低温下用真空泵抽干,并用五氧化二磷或干冰使水汽结冻,熔封安瓿管,于低温下保存。保存期可达5~10年之久。
③ 石蜡油封存法,在斜面菌种培养物上,倒上灭菌后的石蜡油,高出斜面1cm,于4℃冰箱或低温干燥处保存,此法不适用于能利用石蜡油作碳源的微生物,保存期为一年以上。
顶头孢霉特别注意事项
l、微生物菌种应保藏于低温、清洁和干燥的地方,室温放置时问过长会导致菌种衰退;
2、菌种操作应在无菌条件下进行,防止杂菌污染:
3、斜面菌种保藏时间通常为1-2个月,应根据菌种状况及时转接;冻干菌种保藏时间通常为5~10年;
4、菌种使用过程中如出现杂菌污染或菌种生产性能下降,应及时与我公司联系或更换新的菌种。
使优良菌种的性状保持稳定,人为地创造条件,使菌种的新陈代谢活动处于不活泼状态,即选取优良菌种的休眠体(孢子或芽孢)或富有生命力的悬浮液在低温或脱水状态下保存。
风险提示:丁香通仅作为第三方平台,为商家信息发布提供平台空间。用户咨询产品时请注意保护个人信息及财产安全,合理判断,谨慎选购商品,商家和用户对交易行为负责。对于医疗器械类产品,请先查证核实企业经营资质和医疗器械产品注册证情况。
- 作者
- 内容
- 询问日期
文献和实验,发展为今天这样一个种类多、繁殖快、分布广、适应性强的重要类群。 半知菌多腐生于陆地或水中。 1935年, W. B.格罗夫和 1983年, D. L.霍克斯沃思将本亚门下分丝孢菌纲和腔孢菌纲 2纲,约 17000种。有些种是人类和动、植物的致病菌;有些种能导致食品腐败以及原料、器材的腐蚀或变质;有些种的代谢产物可用于制取抗生素(如产生青霉素的青霉、产生头孢霉素的头孢霉等)、有机酸和酶制剂;有些种可用于有害昆虫和杂草的生物防除。同时,半知菌也在生态系统中的物质和能量
可作药用的真菌。中国以真菌作为药材治疗人类疾病有着悠久的历史。早在2550年前,我们的祖先就会用豆腐上生长的霉治疗疮痈。《神农本草经》中记载的药用真菌有茯苓、灵芝、虫草、木耳等。在《本草拾遗》和《本草纲目》中也都有药用真菌的记载。真菌用作现代药物始于20世纪40年代,1940年青霉素提纯作为抗生素首次用于临床试验,从而开创了用抗生素治疗传染病的先例。1956年第二种真菌抗生素——头孢霉素试制成功。这种抗生素不仅具有青霉素的优点,且不易引起过敏反应。甾族化合物的转化是真菌带给医药界的又一类
(Mucorales)真菌大多是腐生菌,引起植物花、果实、块根和块茎的腐烂。1. 根霉属(Rhizopus)菌丝发达,有分枝,分布在基物表面或其内,有匍匐丝和假根。孢囊梗2-3根丛生,在假根相反方向从菌丝上产生,一般不分枝,顶生孢子囊,产生大量孢囊孢子,有囊轴,锣锤形,孢囊孢子单胞,表面有饰纹,接合孢子色深,表面有瘤状突起。取甘薯软腐病(R.nigricans)标本,观察症状特点,注意受害甘薯表面是否有白色毛状物生出?在白色毛状物中是否有黑点?挑取培养皿中培养的根足霉(带少许培养基)制片),镜检小黑点是什么器官
技术资料暂无技术资料 索取技术资料